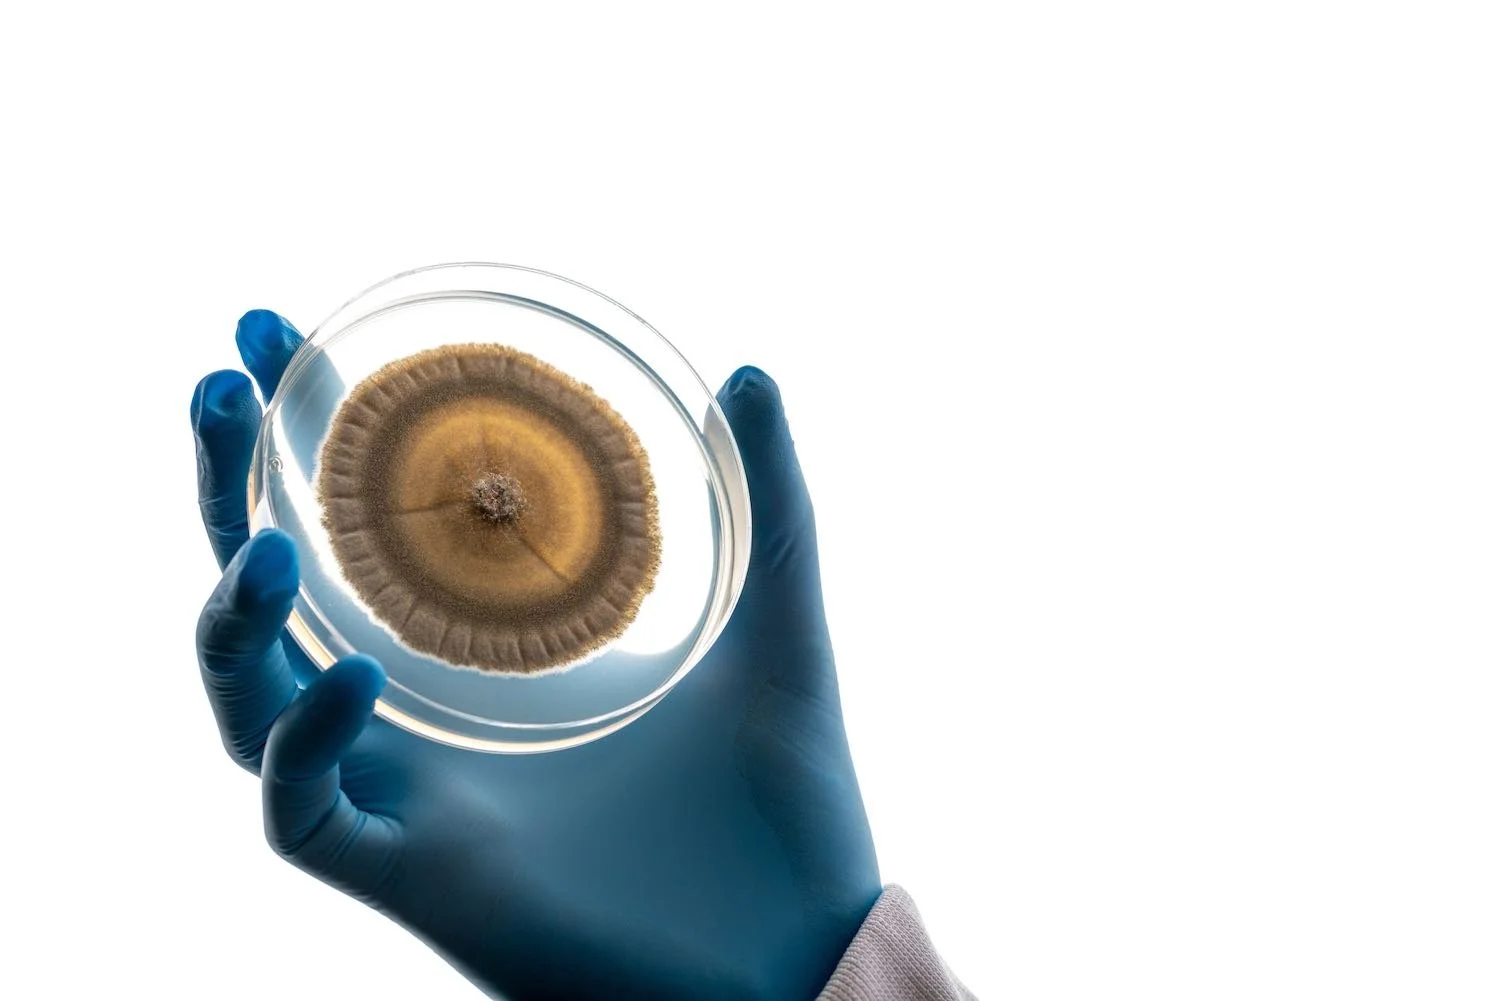

At ROAM, our mission is to safeguard the ruminant livestock industry by providing scalable, science-driven and adoptable solutions that significantly reduce methane emissions, without compromising on productivity or profitability.
.
-

Innovating for a Greener Future:
Our mission is rooted in innovation and adaptation. We believe that the key to solving the climate crisis lies in advancing technologies that go beyond incremental change. By pioneering patented natural fungal organisms and optimising its production at scale, we are setting new standards for methane reduction in agriculture using naturally derived bromoform. Our approach ensures that producers can adopt our solutions easily, without compromising production efficiency or cost, making a meaningful impact on national and global emissions.
-

Empowering the Livestock Industry:
We understand that the livestock industry is at the heart of global food production, and our mission is to empower this sector with tools that enhance both sustainability and productivity. Our products, developed from patented natural fungal microbials, are designed to integrate into existing farming practices reducing barriers to adoption and offers a reliable and effective way to manage methane emissions for intensive and extensive livestock systems. By making our solutions scalable, we aim to support producers in a cost effective transition to more sustainable practices while maintaining profitability and efficiency.
-

Committing to Environmental Stewardship:
At ROAM, we are committed to environmental stewardship and sustainable production practices. We recognise that all sectors of the global economy need to take action to mitigate climate change, and we believe that every tonne of methane reduced now is a better outcome for future generations. Our mission extends beyond technological innovation; it’s about creating a legacy of positive impact for the environment, our rural communities and the livestock sector by utilising our natural fungi microbials to protect natural resources and foster a sustainable future.
-

Leading with Integrity and Collaboration:
Our mission is guided by a strong commitment to collaboration, integrity and transparency. We believe in building partnerships that drive collective action toward shared goals. Whether it’s through collaborating with research institutions, industry leaders, or similar dedicated experts, we are focused on delivering practical results that matter. Our success is measured not just by our technological advancements, but by the real-world impact we achieve in mitigating methane emissions with our innovative, naturally derived solutions.
-
Creating Lasting Impact:
The ultimate goal of ROAM is to create lasting, measurable impact. We envision a future where the livestock industry is a key player in the global effort to address climate change, and we are dedicated to making that vision a reality. Through our patented fungal technology, we aim to drastically reduce methane emissions, contributing to a cleaner environment and a sustainable food system that can thrive for generations to come.